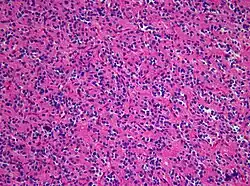

Neurozytom
| Klassifikation nach ICD-11 | |
|---|---|
| 2A00.3 | Zentrales Neurozytom des Gehirns |
| ICD-11: Englisch • Deutsch (Entwurf) | |


Als Neurozytom wird ein seltener gutartiger Hirntumor bezeichnet. Da Rezidive auftreten können, wird der Tumor nach der WHO-Klassifikation der Tumoren des zentralen Nervensystems als Grad II eingeordnet. Die WHO-Klassifikation unterscheidet das typischerweise intraventrikulär im Bereich des Foramen Monroi gelegene zentrale Neurozytom vom selteneren extraventrikulären Neurozytom, das keinen Bezug zum Ventrikelsystem des Gehirns besitzt.
Epidemiologie und Klinik
Neurozytome sind selten. Seit der Erstbeschreibung im Jahre 1982[1] sind weltweit einige 100 Fälle berichtet worden. Das zentrale Neurozytom führt aufgrund seiner intraventrikulären Lage typischerweise zu einer Behinderung des Liquorabflusses und macht sich klinisch als Hydrocephalus bemerkbar. In der Bildgebung stellen sich Neurozytome als nicht selten zystische, variabel Kontrastmittel aufnehmende Raumforderungen dar.
Neuropathologie

Die relativ monomorphen neurozytär differenzierten Tumorzellen bilden feine neuropilartige Fortsätze und Inseln aus. Immunhistochemisch ist mit Expression von neuronalen Markern wie Synaptophysin und NeuN eine neuronale Differenzierung der Tumorzellen nachweisbar, was eine Abgrenzung gegenüber anderen neuroektodermalen Tumoren wie zum Beispiel dem Ependymom erlaubt.
Behandlung und Prognose
Nach vollständiger neurochirurgischer Resektion des Tumors ist die Prognose in der Regel sowohl bei zentralen Neurozytomen als auch bei extraventrikulären Neurozytomen günstig;[2] für zentrale Neurozytome wurde eine 5-Jahres-Überlebensrate von 81 % angegeben.[3] Neben einer unvollständigen Resektion ist insbesondere eine erhöhte proliferative Aktivität mit einer erhöhten Rezidivneigung in Verbindung gebracht worden; solche Tumoren werden in der Literatur auch als atypische Neurozytome bezeichnet. In diesem Fall kann der weitere Krankheitsverlauf unter Umständen durch eine adjuvante Bestrahlung günstig beeinflusst werden.[4][5]
Literatur
Einzelnachweise
- ↑ J. Hassoun, D. Gambarelli, F. Grisoli, W. Pellet, G. Salamon, J. F. Pellissier, M. Toga: Central neurocytoma. An electron-microscopic study of two cases. In: Acta Neuropathol 1982;56, S. 151–156. PMID 7064664
- ↑ D. J. Brat, B. W. Scheithauer, C. G. Eberhart, P. C. Burger: Extraventricular neurocytomas: pathologic features and clinical outcome. In: Am J Surg Pathol. 2001 Oct;25(10), S. 1252–1260. PMID 11688459
- ↑ S. E. Schild, B. W. Scheithauer, M. G. Haddock, D. Schiff, P. C. Burger, W. W. Wong, M. K. Lyons: Central neurocytomas. In: Cancer. 1997; 79, S. 790–795. PMID 9024717
- ↑ D. Rades, S. E. Schild: Treatment recommendations for the various subgroups of neurocytomas. In: J Neurooncol. 2006;77(3), S. 305–309. PMID 16575540
- ↑ J. L. Leenstra, F. J. Rodriguez, C. M. Frechette, C. Giannini, S. L. Stafford, B. E. Pollock, S. E. Schild, B. W. Scheithauer, R. B. Jenkins, J. C. Buckner, P. D. Brown: Central neurocytoma: management recommendations based on a 35-year experience. In: Int J Radiat Oncol Biol Phys. 2007 Mar 15;67(4), S. 1145–1154. PMID 17187939